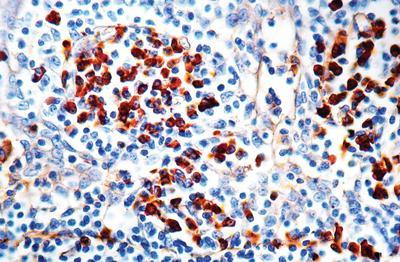

IGG RTU POLYCLONAL AB 6ML ,Each
$ 331.53
|
|
Details:
IgG^ Rabbit, This antibody reacts with gamma-chains of human IgG. Nonspecific antibodies have been removed by solid-phase absorption.
Additional Information
| SKU | 2321397 |
|---|---|
| UOM | EACH |
| UNSPSC | 12352203 |
| Manufacturer Part Number | PDR 018 |
| Product Dimensions | 8X5X4 Inches |
| Product Weight | 1 |

